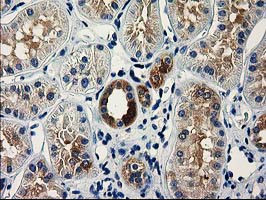
VSIG2 Antibody in Immunohistochemistry (Paraffin) (IHC (P))

Search
OriGene
VSIG2 Monoclonal Antibody (OTI5A10), TrueMAB™
{{$productOrderCtrl.translations['antibody.pdp.commerceCard.promotion.promotions']}}
{{$productOrderCtrl.translations['antibody.pdp.commerceCard.promotion.viewpromo']}}
{{$productOrderCtrl.translations['antibody.pdp.commerceCard.promotion.promocode']}}: {{promo.promoCode}} {{promo.promoTitle}} {{promo.promoDescription}}. {{$productOrderCtrl.translations['antibody.pdp.commerceCard.promotion.learnmore']}}
产品信息
CF502161
种属反应
宿主/亚型
分类
类型
克隆号
抗原
偶联物
形式
浓度
纯化类型
保存液
内含物
保存条件
运输条件
产品详细信息
For reconstitution, we recommend adding 100 µL distilled water to a final antibody concentration of about 1 mg/mL. To use this carrier-free antibody for conjugation experiments, we strongly recommend performing another round of desalting. (Zeba Spin Desalting Columns, 7KMWCO, 0.5 mL, Product # 89882)
靶标信息
CTXL, a cortical thymocyte marker, is a member of the immunoglobulin (Ig) superfamily and has features of both antigen specific receptors and adhesion molecules. This single pass, type I protein contains a signal peptide, an extracellular V type Ig like domain followed by a C2 type Ig like domain and a cytoplasmic tail. Expression levels of CTXL are high in the stomach, colon, prostate, trachea, and thyroid gland, with lower levels observed in bladder and lung tissues. CTXL is not expressed in the thymus. CTXL is developmentally regulated and may be involved in thymocyte selection. It localizes to junctional complexes between endothelial and epithelial cells and may play a role in cell-cell adhesion and transmigration of leukocytes.
仅用于科研。不用于诊断过程。未经明确授权不得转售。
篇参考文献 (0)
生物信息学
蛋白别名: cortical thymocyte receptor (X. laevis CTX) like; Cortical thymocyte-like protein; CT-like protein; V-set and immunoglobulin domain-containing protein 2
基因别名: 2210413P10Rik; CTH; CTXL; UNQ2770/PRO7154; VSIG2
UniProt ID: (Human) Q96IQ7
Entrez Gene ID: (Human) 23584